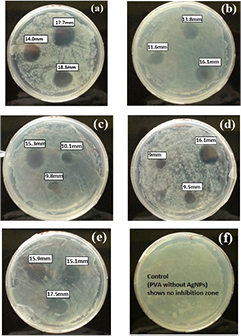
Figure 4.

Abstract
The present study reports the synthesis of antibacterial biodegradable nanocomposite film of poly (vinyl alcohol)-biogenic silver. The biosynthesized silver nanoparticles were used for development of nanocomposite film. Ficus benghalensis leaf extract was used to synthesize silver nanoparticles which are cost effective, environmental friendly and rapid method. The PVA-biogenic silver nanocomposite film was characterized by AFM to determine the morphology of the film surface and confirm the incorporation of silver nanoparticles. The antibacterial activity of the nanocomposite film was investigated against Salmonella typhimurium by means of disk diffusion method. PVA-biogenic silver nanocomposite film shows excellent antibacterial activity against Salmonella typhimurium. This nanocomposite film can be a prominent material for food packaging.
Export citation and abstract BibTeX RIS

Original content from this work may be used under the terms of the Creative Commons Attribution 3.0 licence. Any further distribution of this work must maintain attribution to the author(s) and the title of the work, journal citation and DOI.
1. Introduction
Nanotechnology is the study of engineering and manipulating materials which have at least one of their dimensions in the range of 1–100 nm [1]. When brought down to nanometer scale, the particles fall into the quantum mechanics regime and exhibit a very high surface area to volume ratio. These phenomena are responsible for the altered chemical and physical properties observed in nanomaterials as compared to their bulk counterparts. The unique and tunable properties exhibited by nanomaterials have intrigued researchers all over the world and their potential is being explored in fields such as medical therapeutics and diagnostics [2], drug delivery [3–5], antibacterial nanomedicine [6–16], photocatalysis [19], catalysis [20–24] and energy production [25]. Another such field where nanomaterials have slowly gained importance is the food industry [26]. Nanomaterials are being currently explored for pesticide and fertilizer delivery [27], food quality enhancement [28] and food packaging [29].
Food packaging is an essential component of the food industry as it ensures the quality and stability of processed food till it is consumed. With the growing public awareness about disease transmission caused by microorganisms in food, there has been an increasing demand for antibacterial packaging materials which can prevent bacterial contamination in food without affecting their stability [30]. The conventional food packaging made up of polymeric films of polypropylene, polystyrene and polyethylene terephthalate provide useful gas barrier properties and mechanical properties but they lack biodegradability [31]. Polysaccharide (starch) polymers obtained from biological sources have gained popularity due to their biodegradability but their oxygen transmission rate shows great variation with humidity, thus limiting their use commercially [32].
Several polymer nanocomposites have been explored to create the ideal food packaging material by dispersing nanoscale fillers in polymer matrices. Clay and silicate nanoplatelets,  nanoparticles [33–35], graphene [36], starch nanocrystals [37] and cellulose-based nanofibers [38] have been used as nanofillers for enhancing polymer barrier properties. Although these fillers have enhanced various properties such as flame resistance, thermal properties, wettability and hydrophobicity but these nanocomposites are unable to prevent contamination of food product by microorganisms.
nanoparticles [33–35], graphene [36], starch nanocrystals [37] and cellulose-based nanofibers [38] have been used as nanofillers for enhancing polymer barrier properties. Although these fillers have enhanced various properties such as flame resistance, thermal properties, wettability and hydrophobicity but these nanocomposites are unable to prevent contamination of food product by microorganisms.
Antibacterial packaging membranes can be synthesized by incorporating nanomaterials such as silver, titanium dioxide or copper nanoparticles into the polymer films [39, 40]. Silver nanoparticles (AgNPs) have been preferred for such antibacterial applications over other molecular antibacterial due to their broad spectrum antimicrobial activity. They have also been shown to be effective against antibiotic-resistant bacterial strains [41]. AgNP/Polymer nanocomposites have been reported to exhibit antimicrobial activity against Aspergillus niger, Escherichia coli, Staphylococcus aureus and Candida albicans which are common food contaminants [42–44].
Several methods have been reported for silver nanoparticle synthesis and subsequent incorporation into polymer matrices. However most of these methods use environmentally and biologically hazardous chemicals, such as sodium borohydride and formaldehyde as reducing agents [45–47]. Currently extensive research is being carried out to replace such conventional reducing agents with biological extracts and the use of bio-compatible polymers for stabilization of silver nanoparticles [48]. The use of polymers such as poly vinyl alcohol (PVA), chitosan, carboxy methyl cellulose, sodium alginate and starch along with green synthesized silver nanoparticles can facilitate the synthesis of biodegradable polymer films with antibacterial properties for food packaging [49–51].
In this study, we have developed a biodegradable poly vinyl alcohol- biogenic silver nanocomposite film as an antibacterial packaging material. The silver nanoparticles were synthesized using Ficus benghalensis leaf extract [19]. The antibacterial activity of nanocomposite film was analyzed against Salmonella typhimurium by means of disk diffusion methods.
2. Experimental
2.1. Materials
The standard culture of S. typhimurium was obtained from Department of Microbiology, College of Life Sciences, Gwalior, India. F. benghalensis leaves were acquired from campus of Amity University Uttar Pradesh (AUUP), Noida, India. Silver nitrate  and poly (vinyl alcohol) were purchased from Qualigens Fine Chemicals, Mumbai, India. Luria Bertani (LB) was purchased from Hi-media, Mumbai, India.
and poly (vinyl alcohol) were purchased from Qualigens Fine Chemicals, Mumbai, India. Luria Bertani (LB) was purchased from Hi-media, Mumbai, India.
2.2. Synthesis silver nanoparticles and PVA-silver nanocomposites
2.2.1. Biosynthesis of silver nanoparticles.
We have developed biosynthesis method for silver nanoparticles using F. benghalensis leaf extract [19]. Briefly, the fresh leaves of F. benghalensis were collected and thoroughly washed by deionized water and dried on room temperature. Leaves (25 g) were cut and boiled in deionized water to prepare leaf extract. Silver nitrate ( ) solution was prepared into 45 ml deionized water. 5 ml leaf extract was added drop by drop into the silver nitrate solution with constant stirring at
) solution was prepared into 45 ml deionized water. 5 ml leaf extract was added drop by drop into the silver nitrate solution with constant stirring at  for preparation of silver nanoparticles. The biosynthesized silver nanoparticles were characterized by UV-vis spectroscopy. The surface plasmon resonance (SPR) was analyzed by scanning the sample in the range of 200–800 nm. X-ray diffraction (XRD) patterns were analyzed to lattice plane. Further the nanoparticles were characterized by transmission electron microscopy (TEM) and energy dispersive x-ray spectroscopy (EDX).
for preparation of silver nanoparticles. The biosynthesized silver nanoparticles were characterized by UV-vis spectroscopy. The surface plasmon resonance (SPR) was analyzed by scanning the sample in the range of 200–800 nm. X-ray diffraction (XRD) patterns were analyzed to lattice plane. Further the nanoparticles were characterized by transmission electron microscopy (TEM) and energy dispersive x-ray spectroscopy (EDX).
2.2.2. Preparation of PVA-silver nanocomposite film.
Nanocomposite film was prepared by taking 8% Poly (vinyl alcohol) and dissolved in deionized water at  with constant stirring. After some time a transparent solution was prepared. Subsequently, biosynthesized silver nanoparticles colloidal solution was added into the PVA solution at a concentration of
with constant stirring. After some time a transparent solution was prepared. Subsequently, biosynthesized silver nanoparticles colloidal solution was added into the PVA solution at a concentration of  ,
,  and
and  . Finally the solution was transferred onto a Teflon covered glass plate and dried at
. Finally the solution was transferred onto a Teflon covered glass plate and dried at  . The prepared films with different concentration of silver nanoparticles were washed with water and further dried at room temperature. Atomic force microscopy was used to analyze the topography of a given sample along with its size. AFM uses a cantilever mounted tip to analyze the surface of the specimen. Force of attraction between the tip and the sample surface results in deflections which are then used to measure the surface topography.
. The prepared films with different concentration of silver nanoparticles were washed with water and further dried at room temperature. Atomic force microscopy was used to analyze the topography of a given sample along with its size. AFM uses a cantilever mounted tip to analyze the surface of the specimen. Force of attraction between the tip and the sample surface results in deflections which are then used to measure the surface topography.
2.3. Antibacterial activity of nanocomposite films
Inhibition zone analysis was performed by disk diffusion method. The nanocomposite films were cut into small disks of 4 mm diameter. LB solid media was prepared and S typhimurium culture was spread on it. The nanocomposite films disk was placed on the culture plate to evaluate the zone of inhibition. The plates were incubated at  for 24 h and the inhibition zone was measured.
for 24 h and the inhibition zone was measured.
3. Results and discussion
3.1. Biosynthesis silver nanoparticles (AgNPs)
Silver nanoparticles have already been synthesized by biological route using Ficus benghalensis [1]. UV-vis spectra were recorded as from 200 to 800 nm to analyze the surface plasmon resonance (SPR). Figure 1(a) shows that the absorbance was increased with increasing time of reaction which indicates the formation of nanoparticles. The SPR was occurred at 410 nm which is in the good agreement of SPR of silver nanoparticles. Figure 1(b) shows the x-ray diffraction (XRD) pattern of biosynthesized silver nanoparticles. A characteristic peak occurred at  which corresponding to the (222) set of lattice plane, matching with JCPDS file No. 04-0783. TEM micrograph reveals that the synthesized nanoparticles are biosynthesized in the range of 20–90 nm with spherical shape (figure 2(a)). The micrograph also indicates that the presence of bio-capping layer which provide stability. EDX mapping and pointer both show the presence of elemental silver in biosynthesized nanoparticles (figures 2(b) and (c)). The presence of copper signal in EDX pointer is depicting due to use of copper grid.
which corresponding to the (222) set of lattice plane, matching with JCPDS file No. 04-0783. TEM micrograph reveals that the synthesized nanoparticles are biosynthesized in the range of 20–90 nm with spherical shape (figure 2(a)). The micrograph also indicates that the presence of bio-capping layer which provide stability. EDX mapping and pointer both show the presence of elemental silver in biosynthesized nanoparticles (figures 2(b) and (c)). The presence of copper signal in EDX pointer is depicting due to use of copper grid.
Figure 1. (a) UV-vis spectra showing absorption with function of time. (b) XRD pattern of biosynthesized silver nanoparticles using leaf extract. Figures are reproduced from Tripathi et al [1], with the permission from Elsevier science.
Download figure:
Standard image High-resolution imageFigure 2. (a) TEM micrograph of biosynthesized silver nanoparticles using Ficus benghalensis leaf extract. (b) EDX mapping of silver nanoparticles (c) EDX pointer of biogenic silver nanoparticles. Figures are reproduced from Tripathi et al [1], with the permission of Elsevier science.
Download figure:
Standard image High-resolution image3.2. Atomic force microscopy of Ag NP/PVA
A thin film of the silver nanoparticles-Poly vinyl alcohol solution was casted on a glass slide and analyzed by AFM to determine the size of the AgNPs and the morphology of the nanocomposite thin film. AFM micrograph depicted the incorporation of the AgNPs within the PVA layer and with spherical morphology (figures 3(a)–(c)). The average particle size was found to be 32 nm (figure 3(d)). Furthermore, AFM indicated that the particles were not agglomerated within the PVA matrix.
Figure 3. Morphological features of Ag/PVA nanocomposite film analyzed by AFM—(a) planar Surface (b) 3D view of the surface (c) nanoparticle with spherical shape (d) histogram-size distribution.
Download figure:
Standard image High-resolution image3.3. Analysis of antibacterial activity
The antibacterial activity of PVA-silver nanocomposite film was tested against Salmonella typhimurium by disk diffusion method. After 24 h of incubation period, regions with no bacterial growth were observed around the nanocomposite film disks in the culture plates. The antibacterial activity of the nanocomposite film was evaluated by analyzing the diameter of these inhibition zones. The diameter of the inhibition zones ranges from 9 mm to 18.3 mm and was seen to increase with increasing the concentration of silver nanoparticles in the film (figure 4). The maximum inhibition zone of 18.3 mm was observed at  silver nanoparticles.
silver nanoparticles.
Figure 4. Zone of inhibition formation with PVA-silver nanocomposite against S typhimurium.
Download figure:
Standard image High-resolution image4. Conclusions
In this study, biogenic silver nanoparticles were synthesized using F. benghalensis leaf extract. This method is rapid, cost effective, and environmental friendly. Synthesized silver nanoparticles were mixed with the 8% of PVA solution to develop nanocomposite film. The developed nanocomposite film was characterized by atomic force microscopy (AFM). The antibacterial activity of nanocomposite films was evaluated by the means of disk diffusion method. It was found that the nanocomposite films show excellent antibacterial activity against Salmonella typhimurium. The inhibition zones were increased with increasing concentration of biogenic silver nanoparticles in the film. The developed nanocomposite films could be prominent materials for food packaging.
Acknowledgment
RMT and RNP are grateful to the Amity University Uttar Pradesh, Noida, India, for providing excellent facility for the above work.